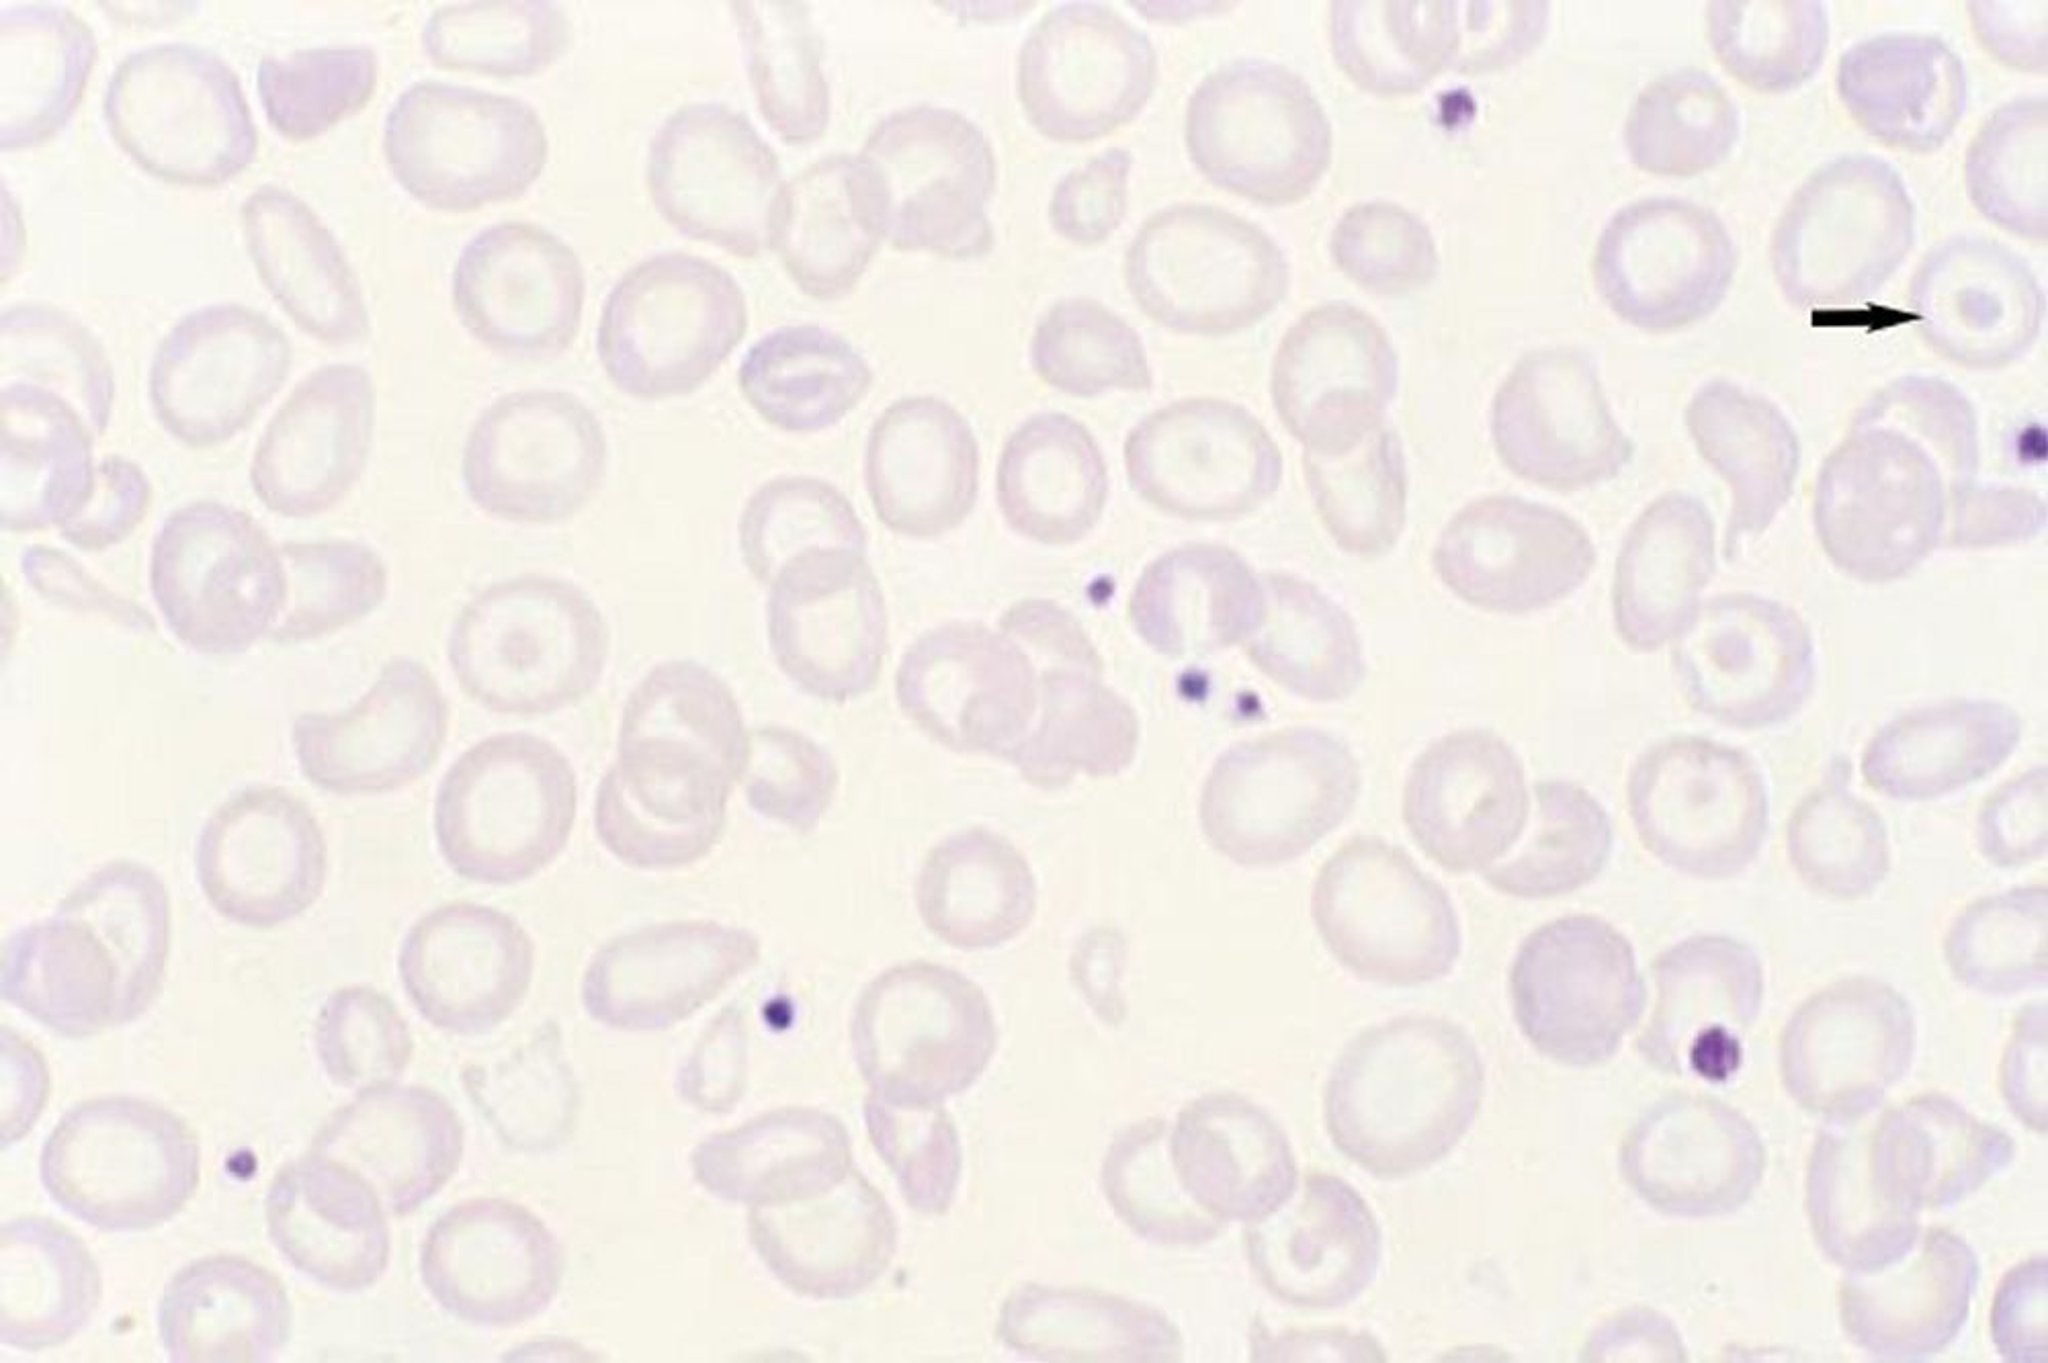
Dianocitos

Dianocitos
Las células en blanco de tiro (dianocitos) (eritrocitos delgados con un punto central de hemoglobina; flecha) se deben a un desequilibrio entre el volumen de la célula y su contenido de hemoglobina y caracterizan a la talasemia, otras hemoglobinopatías (p. ej., enfermedad de hemoglobina C y enfermedad de hemoglobina S-C), pero también pueden ocurrir después de la esplenectomía y en la enfermedad hepática.
By permission of the publisher. From Tefferi A, Li C. In Atlas of Clinical Hematology. Edited by JO Armitage. Philadelphia, Current Medicine, 2004.
En estos temas